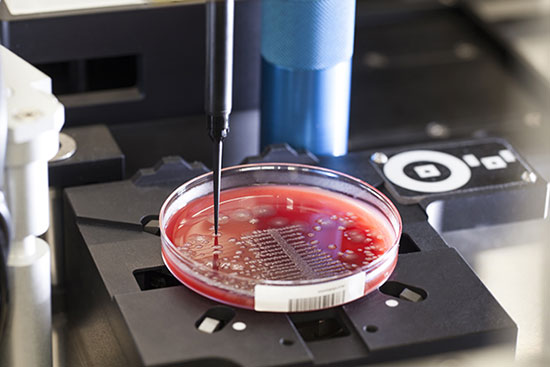
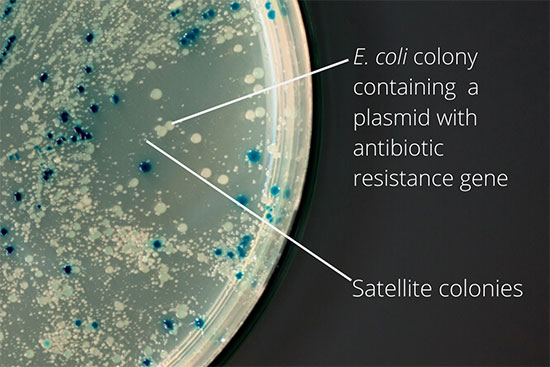
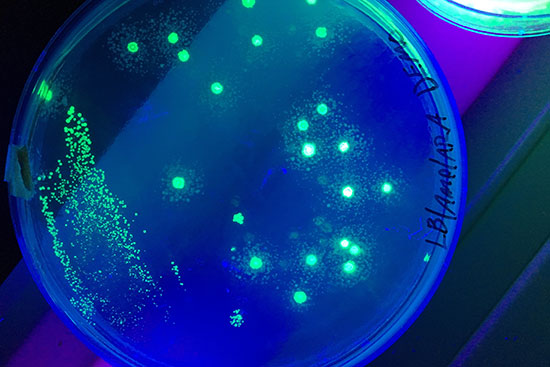

Molecular genetics and cytogenetics services
Some of the techniques presented in Histogenotech
- Perform ELISA, Western blot and flow cytometry
- Bacterial Transformation by chemical method and electroporation
- Bacterial colony culture, plasmid purification and virus generation from vector
- Perform PCR cloning on expression vectors
- Design, order and check the accuracy of vector construction
- Design expressive vectors
- Cell transduction with virus
- Labeling the cell with GFP vector
- Production of recombinant cell line
- Educational cloning of genes for protein expression
- SDS PAGE technique
- Kumasi Blue staining

Today, due to the increasing concerns of genetics studies, especially in Iran, the application of various genetic tests in the fields of stem cell research, diagnostics, treatment, prognosis and many other areas become very important. Histogenotech research laboratory intends to introduce the processes, applications, disadvantages and advantages of some of the most widely used genetic tests in both cytogenetics and molecular genetics after briefly introducing various types of genetic tests based on their functional purpose.
Therefore, in the field of cytogenetics, genetic manipulation tests, flow cytometry, FISH, CGH and in the field of molecular genetics, various methods based on PCR, PCR quantification and new generation sequencing techniques (NGS) are introduced.